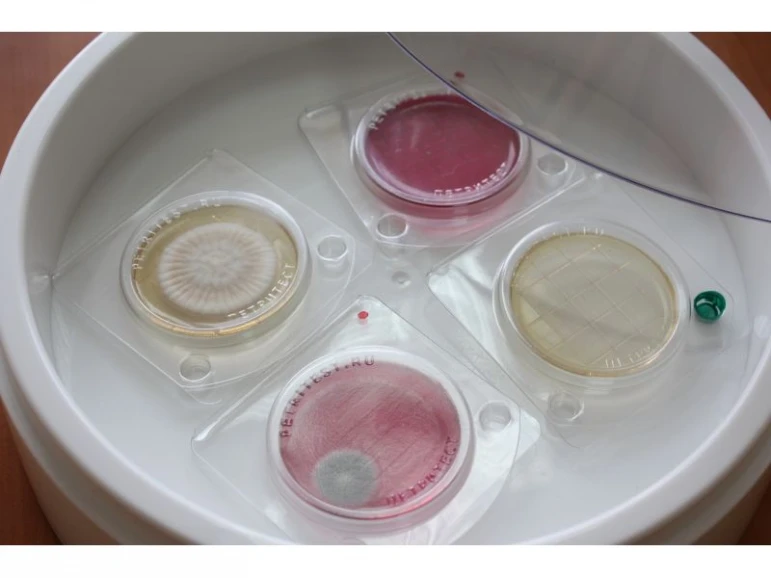

We improve the functionality every day. Work is underway to update the site. But you can already use the available functions of the site!
English
Announcements
Create an ad
Petritest substrate test for coliforms
ID650en:Petritest substrate test for coliforms
Цена: 766 ₽
ID650en: Petritest substrate test for coliforms
Price: 766 ₽
"Alternative", Scientific and Production Association, LLC
Business
Location
Condition: New
Bidding: No
Description
Petritest rapid test for detection of coliform bacteria (CGB)
The company NPO "Alternativa" offers you an innovative and convenient tool for microbiological control - the Petritest® rapid test (substrate) for detection of coliform bacteria (CGB), such as Escherichia coli, Citrobacter, Enterobacter, Klebsiella, Hafnia.
Product characteristics:
- Name: Petritest® (substrate for detection of CGB)
- Type: Rapid test for detection of coliform bacteria
- Substrate: Nutrient, modified agar-based medium
- Application: Food enterprises, control of surfaces, water, air, as well as for hygienic assessment of hand cleanliness of personnel
- Convenience: Does not require a laboratory or special equipment
- Cost-effective: The cost of one test is lower than domestic and foreign analogues
- Ease of use: Just place the sample on the test, thermostat and get the results
Advantages of using Petritest® for microbiological control:
- Rapid detection of coliform bacteria in food, water, on surfaces and in air samples
- Improving safety in food production
- Convenience and ease of use without the need for a laboratory and specialized equipment
- Cost savings due to the use of affordable tests with proven effectiveness
NPO Alternative has been successfully producing microbiological rapid tests since 2016, and we are proud of the quality of our products. We offer reliable solutions for your enterprises in the field of microbiological control, ensuring safe production and a high level of hygiene.
Every day the number of businesses and entrepreneurs using Petritest is growing, thanks to its simplicity, convenience and excellent efficiency. For more information and consultations, contact us via email or WhatsApp, indicated in the company profile on Mytrade.kz. Professional quality control and hygiene standards at food enterprises using the Petritest® express test for detecting E. coli is available on Mytrade.kz.
ID: 650
Published 24.01.2025
34